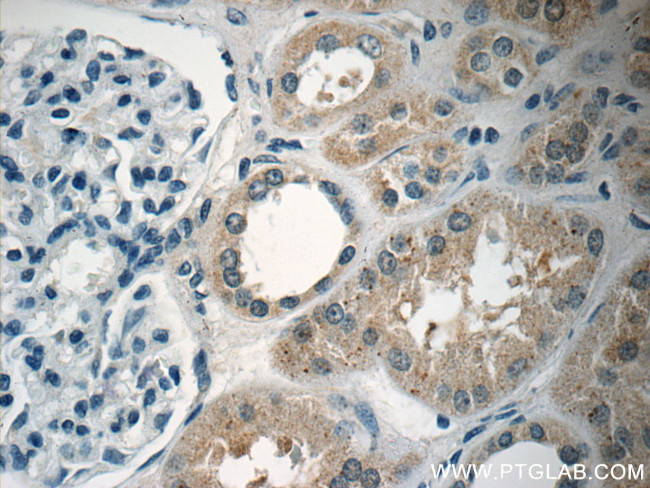
ARHGEF18 Antibody in Immunohistochemistry (Paraffin) (IHC (P))

Search
Proteintech
ARHGEF18 Polyclonal Antibody
{{$productOrderCtrl.translations['antibody.pdp.commerceCard.promotion.promotions']}}
{{$productOrderCtrl.translations['antibody.pdp.commerceCard.promotion.viewpromo']}}
{{$productOrderCtrl.translations['antibody.pdp.commerceCard.promotion.promocode']}}: {{promo.promoCode}} {{promo.promoTitle}} {{promo.promoDescription}}. {{$productOrderCtrl.translations['antibody.pdp.commerceCard.promotion.learnmore']}}
产品信息
11243-1-AP
种属反应
宿主/亚型
分类
类型
抗原
偶联物
形式
浓度
规格
纯化类型
保存液
内含物
保存条件
运输条件
产品详细信息
Immunogen sequence: MSQGMQRMH LETLQQVDKW PLCGPLACSE LLQLTVRSLE GWRKEVLGSI KGAGTSQGGE IHPRSSSGGE RAHVKPCSAP QALVVGLGPG (1-89 aa encoded by BC014994 )
靶标信息
Rho GTPases are GTP binding proteins that regulate a wide spectrum of cellular functions. These cellular processes include cytoskeletal rearrangements, gene transcription, cell growth and motility. Activation of Rho GTPases is under the direct control of guanine nucleotide exchange factors (GEFs). The protein encoded by this gene is a guanine nucleotide exchange factor and belongs to the Rho GTPase GFE family. Family members share a common feature, a Dbl (DH) homology domain followed by a pleckstrin (PH) homology domain. Alternatively spliced transcript variants encoding different isoforms have been identified.
仅用于科研。不用于诊断过程。未经明确授权不得转售。
篇参考文献 (0)
生物信息学
蛋白别名: 114 kDa Rho-specific guanine nucleotide exchange factor; p114-Rho-GEF; Rho guanine nucleotide exchange factor 18; Rho-specific guanine nucleotide exchange factor p114; Rho/Rac guanine nucleotide exchange factor (GEF) 18; SA-RhoGEF; Septin-associated RhoGEF; unnamed protein product
基因别名: AI467246; ARHGEF18; D030053O22Rik; KIAA0521; P114-RhoGEF; p114RhoGEF; RP78; SA-RhoGEF
UniProt ID: (Human) Q6ZSZ5, (Mouse) Q6P9R4
Entrez Gene ID: (Human) 23370, (Mouse) 102098